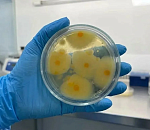
В астраханской селедке нашли 350-кратное превышение плесени

Важно!
Использование материалов, размещенных на информационно-новостном ресурсе «ПУНКТ-А», допускается ТОЛЬКО С РАЗМЕЩЕНИЕМ АКТИВНОЙ ГИПЕРСЫЛКИ. Перед чтением материалов сайта "ПУНКТ-А" проконсультируйтесь с юристом и врачом, по возможности ознакомьтесь с инструкцией по применению всех упомянутых товаров и услуг; имеются противопоказания. Комментарии читателей сайта размещаются без предварительного редактирования. Редакция оставляет за собой право удалить их с сайта или отредактировать, если указанные сообщения содержат ненормативную лексику, оскорбления, призывы к насилию, являются злоупотреблением свободой массовой информации или нарушением иных требований закона. Материалы с плашками "Новости компаний", "Промо", "Партнерский материал", "Политические новости", "Пресс - релиз" публикуются на правах рекламы.
Инфо
СМИ СЕТЕВОЕ ИЗДАНИЕ ИНФОРМАЦИОННО-НОВОСТНОЙ РЕСУРС "ПУНКТ-А" (свидетельство Роскомнадзора ЭЛ № ФС 77 – 67475 от 18.10.2016 г.)
Учредитель - главный редактор Варначкин А. А.
Телефон редакции. +7-908-616-0293.
E-mail редакции: punkt20102010@gmail.com